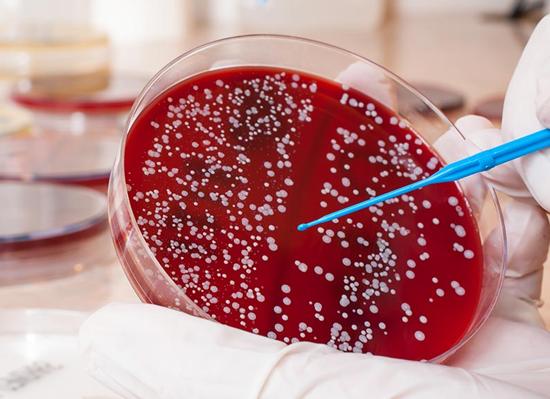
Кровь на стерильность это что

Анализ крови на сывороточное железо
Главная » Анализ крови » Анализ крови на сывороточное железо
В нашем организме существует немалое количество разновидностей образований, веществ и соединений, одним из важнейших элементов является железо. Оно, в свою очередь, также имеет свои подвиды: транспортное, депонированное и функциональное. Большая часть железа находится в крови, в составе дыхательных пигментов: гемоглобина, миоглобина, цито хромов, некоторых железосодержащих пигментов. Недооценивать роль железа в организме, не стоит. Этот элемент отвечает за выполнение многих функций, например за транспортировку кислорода в клетки, органы и ткани, производство ДНК, процесс кроветворения, холестериновый обмен, и многие другие обменные, энергетические и окислительно-восстановительные процессы. Подробнее ...